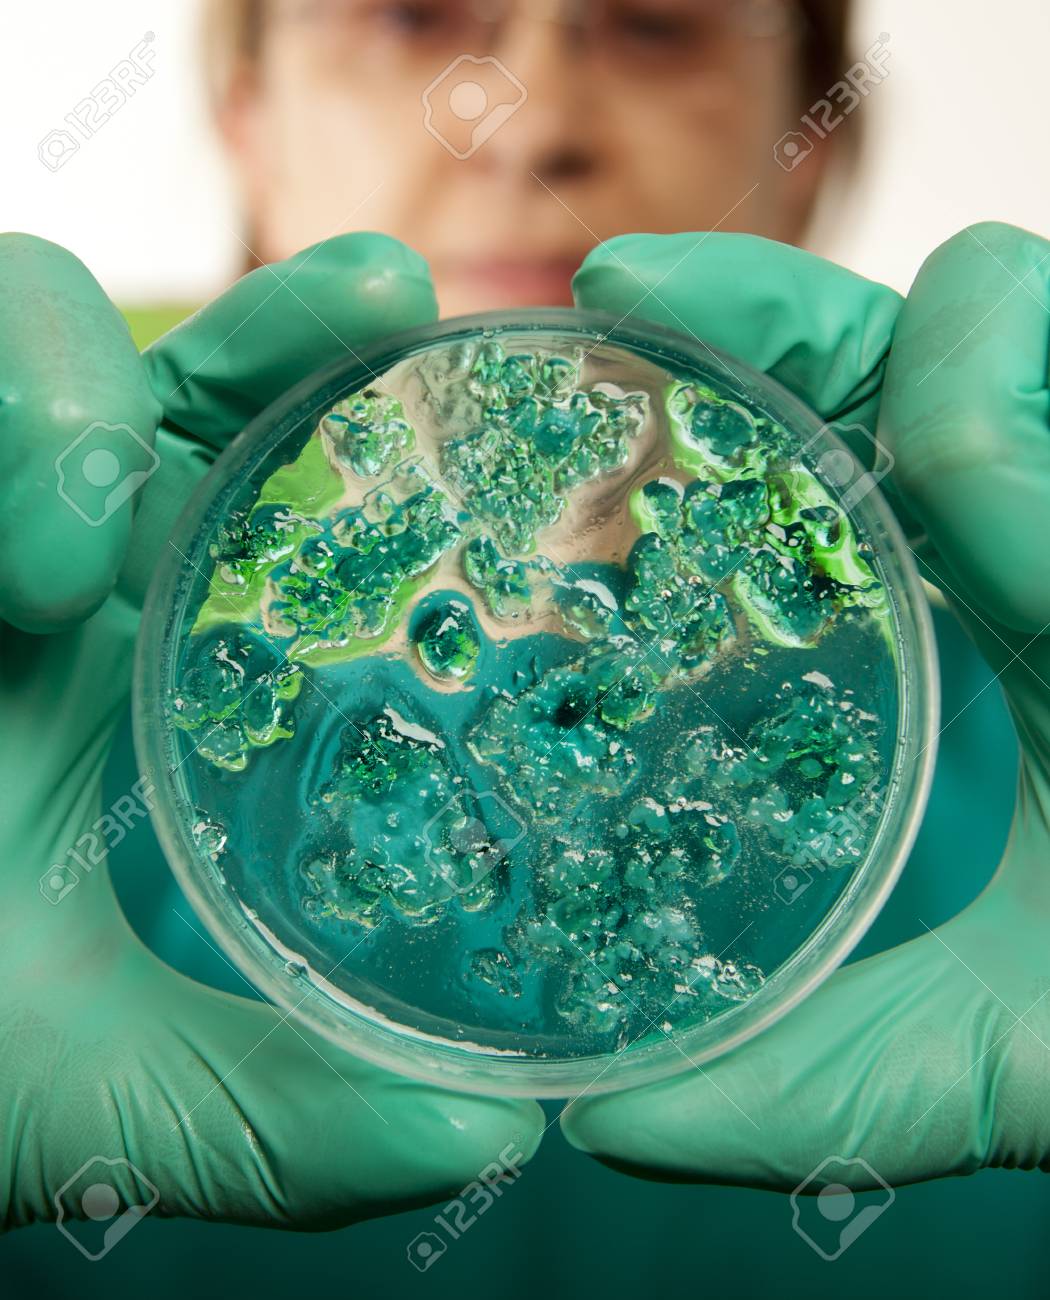
etiam-dictum-ipsum-a-felis

Download
Close
Автор:
id:
Ключевые слова:
agents, bacteria, biochemistry, biology, cells, cholera, concept, conditions, controlled, dish, drugs, ebola, epidemic, equipment, experiments, facility, female, fever, flare, flu, gloves, green, growth, hand, health, holding, hygiene, infection, infectious, lab, laboratory, life, lights, measure, petri, poison, quarantine, research, results, safety, scientific research, scientist, symbol, technology, toxicant, toxin, virus, work,





